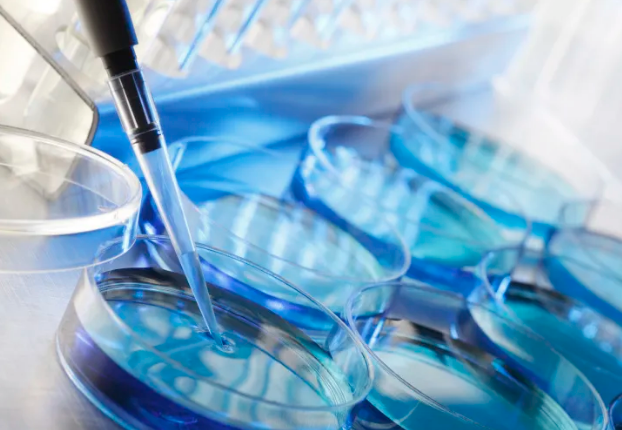
image.png

日本干細胞移植技術(shù)怎么樣,詳解其特點及技術(shù)現(xiàn)狀
2024-09-03 14:24:55 來源: 小編 咨詢醫(yī)生
日本在干細胞研究和移植技術(shù)方面一直處于世界領(lǐng)先地位,尤其是在再生醫(yī)學(xué)、腫瘤治療以及神經(jīng)系統(tǒng)疾病的治療上。以下將詳細探討其技術(shù)特點和當(dāng)前的技術(shù)現(xiàn)狀。
1.技術(shù)背景
干細胞移植技術(shù)是利用干細胞的再生和分化能力,用于治療各種疾病的方法。日本的干細胞研究起步較早,尤其以誘導(dǎo)多能干細胞(iPSC)研究而聞名。日本科學(xué)家山中伸彌于2006年首次成功從成體細胞中重編程得到誘導(dǎo)多能干細胞,獲得了2012年諾貝爾醫(yī)學(xué)獎。這一技術(shù)為干細胞的應(yīng)用開辟了新的視角。
2.技術(shù)特點
(1)誘導(dǎo)多能干細胞的應(yīng)用
日本的干細胞技術(shù)尤為突出的是iPSC的應(yīng)用,這種細胞不僅可以自我更新,還能分化為多種類型的細胞。這在神經(jīng)退化性疾?。ㄈ缗两鹕。┑难芯恐?,提供了新的治療策略。
(2)個性化細胞治療
干細胞技術(shù)的進步使得個體化治療成為可能。醫(yī)生可以根據(jù)患者的基因信息,利用iPSC從患者自身細胞重建個性化的干細胞,從而減少免疫排斥反應(yīng)。
(3)綜合性移植技術(shù)
日本的醫(yī)療團隊在干細胞移植技術(shù)的整體性上具有較高的整合性。通過與基因工程、組織工程相結(jié)合,形成了復(fù)合型的治療方案,提高了治愈率。
3.技術(shù)現(xiàn)狀
(1)臨床應(yīng)用與研究
日本在干細胞移植技術(shù)的臨床應(yīng)用方面已經(jīng)有了一定的進展。例如,針對血液病的造血干細胞移植已成為常見的治療手段。此外,在神經(jīng)、心血管等領(lǐng)域,研究團隊正在進行臨床實驗,以驗證iPSC的安全性和有效性。
(2)倫理監(jiān)管
日本在干細胞研究方面的倫理監(jiān)管相對嚴格,確保了技術(shù)的發(fā)展和應(yīng)用在倫理框架內(nèi)進行。政府和相關(guān)機構(gòu)對臨床試驗的審批過程非常重視,以確?;颊叩陌踩c權(quán)益。
(3)前沿研究
隨著技術(shù)的發(fā)展,許多日本科研機構(gòu)和大學(xué)正在積極探索新的干細胞來源如臍帶血、胎盤等,并推動這些細胞在臨床上的應(yīng)用,助力更廣泛的疾病治療。
4.未來展望
展望未來,日本的干細胞移植技術(shù)將持續(xù)發(fā)展。通過更深入的基礎(chǔ)研究和臨床應(yīng)用實驗,預(yù)計能在更廣泛的疾病領(lǐng)域改善療效。同時,隨著國際合作的加強和技術(shù)的不斷進步,干細胞技術(shù)有望為全球醫(yī)學(xué)發(fā)展帶來新的機遇。
結(jié)論
綜上所述,日本干細胞移植技術(shù)在理論研究和臨床應(yīng)用方面取得了顯著進展,具有獨特的技術(shù)優(yōu)勢和良好的未來前景。隨著技術(shù)的不斷完善,它將在再生醫(yī)學(xué)領(lǐng)域發(fā)揮越來越重要的作用。
文章來源:https://www.2008eshop.cn/ganxibao/37342.html
-
上一頁: 植物干細胞激活抗衰的原理和作用
- 2024-10-14博雅生物干細胞存儲服務(wù)哪家強?如何選擇?
- 2024-10-23造血干細胞如何轉(zhuǎn)化為血小板?過程解析
- 2024-10-29東陽生物干細胞如何發(fā)揮作用?其臨床應(yīng)用有哪些優(yōu)勢?
- 2024-09-27廣州貝拉國際醫(yī)療干啥的啊
- 2024-10-16美容干細胞研究視頻,如何在家進行護膚實驗?
- 2024-11-04全國前十大干細胞公司有哪些
- 2024-08-15自體干細胞移植多少錢一次
- 2024-09-11美國干細胞治療腎衰竭最新進展
- 2024-09-10怎么打干細胞效果比較好,干細胞幾種注射方法
- 2024-09-03溫州牙髓干細胞功效是什么,牙髓干細胞的四大優(yōu)勢
- 2024-08-29干細胞抗衰優(yōu)勢,保持青春的秘密武器
- 2024-07-23哈爾濱醫(yī)院干細胞,哈爾濱醫(yī)院干細胞移植費用高嗎
- 2024-10-11干細胞治療癲癇需要多久見效?真的有效果嗎?
- 2024-08-07干細胞治療脊髓損傷,干細胞修復(fù)脊髓治療費用多少
- 2024-10-09造血干細胞可以分化成什么細胞,關(guān)鍵因素是什么?
- 2024-09-01骨髓干細胞移植需要配型嗎,移植前的配型要求
- 2024-09-27造血干細胞儲存流程復(fù)雜嗎?哪些機構(gòu)提供儲存服務(wù)?
- 2024-08-27南京儲存干細胞的價格,不同類型干細胞儲存費用
